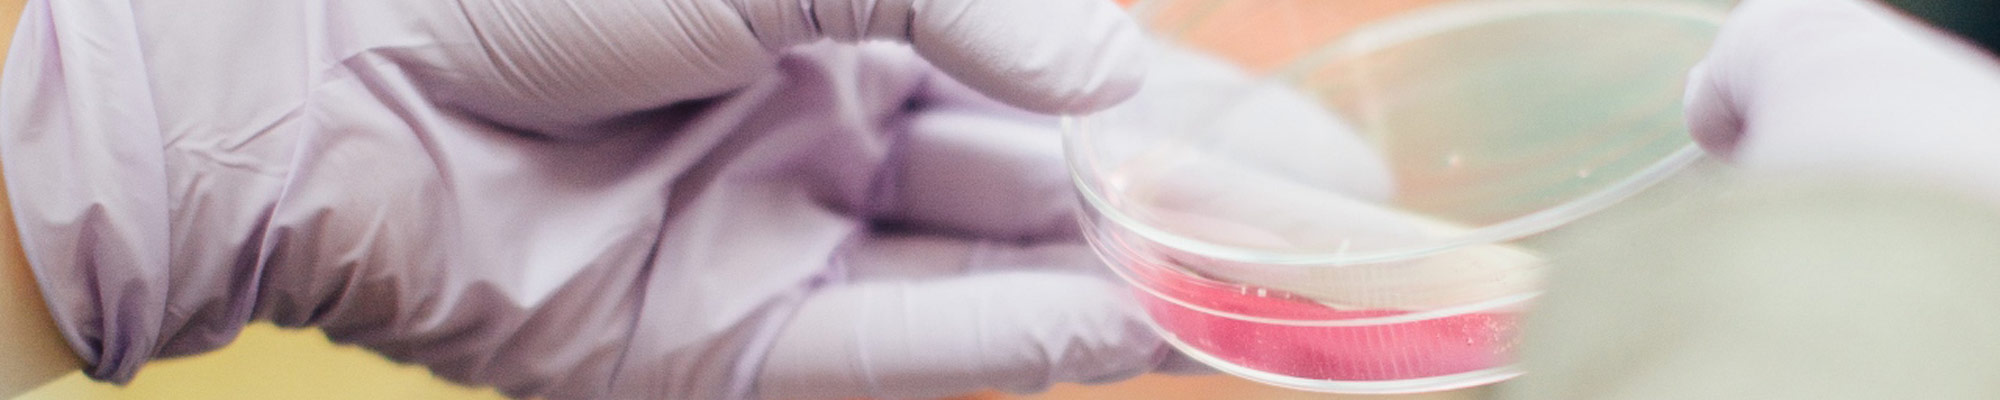

Venture Capital Trusts
Access a portfolio of fast growing smaller UK companies through a Venture Capital Trust, benefitting from attractive initial tax reliefs and the potential for tax-free income.
What are VCTs?
Venture Capital Trusts (VCTs) are listed investment companies that invest in smaller UK businesses. Introduced in 1995, they were designed to encourage long term investment by offering attractive tax incentives.
Small and medium-sized enterprises are central to the UK economy and rely on growth capital to innovate and expand. Venture Capital Trusts provide a vital link between private investors and these businesses, delivering essential equity funding while offering a strong track record of tax efficient income and capital growth.
Investment in the Maven VCTs provides access to a diversified portfolio of high growth UK businesses, with the potential for tax free returns over the life of the investment.
Risk warning
VCT shares should be seen as a long-term investment. A VCT’s underlying investments will normally be in unlisted companies whose securities are not publicly traded and are therefore likely to be illiquid and carry substantially higher risk than investments in larger, listed companies. The value of VCT shares, and the level of income derived from them, may fall as well as rise and investors may not get back the money originally invested. Existing tax levels and reliefs may change and the value of reliefs depends on personal circumstances. Past performance is not a guide to future performance.
Reasons to invest in Venture Capital Trusts
Tax-free dividends and growth
VCTs pay tax free dividends to shareholders, and gains are exempt from Capital Gains Tax on sale of shares.
Tax relief of up to 20%
Initial income tax relief of up to 20% on the amount subscribed for new VCT shares (subject to the investor’s tax circumstances and retaining the shares for at least five years).
Diversified portfolios
Access to highly diversified portfolios of carefully selected private and AIM listed UK companies.
Backing British businesses
Supporting the future of British business, innovation and job creation.
The Maven VCTs
Maven is one of the most active managers in the VCT sector. Our team has a wealth of experience that allows us to identify early-stage businesses with the potential for substantial growth, and then to add value to those businesses in order to generate attractive returns for our VCT investors.
5
highly diversified, established VCTs.
£400M+
has been raised over 15 consecutive years of VCT fundraising.
36
new private company investments completed since January 2021.
14
profitable private company realisations since January 2021, with money multiple returns of up to 8.2x.
6%
target annual dividend yield (% of NAV per share) across the Income and Growth VCTs.
25
experienced professionals sourcing, executing, and managing VCT investments.
Alternative Investment Market (AIM)
Maven is one of the few managers in the VCT market able to offer a hybrid private company and AIM investment strategy, providing access to a wider range of VCT qualifying opportunities. Our dedicated London based AIM team has many years' experience of sourcing and transacting AIM investments across all sectors.
Maven VCTs
Maven manages five established VCTs, each with a large, highly diversified portfolio of carefully selected early-stage businesses with significant potential for growth.

Maven Income and Growth VCT

Maven Income and Growth VCT 3

Maven Income and Growth VCT 4

Maven Income and Growth VCT 5

Maven Renovar VCT
Frequently asked questions
What is a Venture Capital Trust (VCT)?
A VCT is an investment company whose shares are listed on the London Stock Exchange, and is one of the most tax-efficient vehicles available to UK investors. A VCT is run by a specialist fund manager and aims to generate capital gains and income for its shareholders by investing in emerging companies with high growth potential. Although investment in earlier-stage businesses involves a higher level of risk than investment in larger, listed businesses, VCTs offer significant tax benefits for individual investors including the potential to provide a supplementary source of income.
What are the tax benefits of investing in new VCT shares?
- Initial Income Tax relief of up to 20% on subscription*
- Dividends are paid free of Income Tax
- Gains made on the disposal of the shares are free from Capital Gains Tax.
*In order for the initial tax relief to be retained, the shareholder must hold the new shares for at least five years after investment. Initial income Tax relief is generally available on a maximum investment level of £200,000 in the tax year, and is restricted to the amount which reduces the income tax liability to zero for the year of subscription – however eligibility for tax reliefs depends on an investors specific circumstances and Maven cannot advise on taxation.
It is worth noting that VCT Shares purchased on the open (secondary) market also offer tax-free dividends and exemption from Capital Gains Tax on disposal, but that they do not benefit from Initial Income Tax relief (though there is also no tax-related five year minimum holding period).
How can I buy and sell VCT Shares?
As well as investors subscribing for new VCT shares through Share offers, which many VCTs will launch periodically and allow investors to benefit from up to 20% initial tax relief, VCT shares can be purchased in the open ('secondary’) market.
VCT shares are sold in the open ('secondary’) market, just like any other shares listed on the London Stock Exchange.
Maven cannot advise on the sale or purchase of VCT shares, but if you are interested in buying or selling shares in the Maven VCTs you should contact your broker/adviser and request that:
- For the Maven Income and Growth VCTs, they contact Shore Capital Stockbrokers Limited (020 7647 8132), and
- For secondary market dealing in Maven Renovar VCT PLC shares, please contact your stockbroker or an online platform. Market makers do not deal with the public directly.
Have I received a fraudulent contact about my shares?
VCT Boiler Room Scams
Some shareholders have received unsolicited calls from organisations offering to buy their VCT shares at prices much higher than current market values, or to sell non-tradable, overpriced, high risk or even non-existent securities. Whilst the callers may sound credible, shareholders should be aware that their intentions are often fraudulent. If you receive such a call, you should exercise caution and take note of the advice available from the ACTION FRAUD website as well as consulting the Financial Conduct Authority (FCA) website (which contains valuable information on how to avoid investment and pension scams).
We have also received reports of fictitious firms purporting to be Maven or affiliated with Maven. Examples of the company names being used are as follows:
- Maven Investor (Jan 2021) - maveninvestor.co
- Bitmantic (April 2021) - bitmantic.com
- MTrading Investment (March 2021) - mtradinginvestment.com
If you have any doubts about who you are dealing with always seek professional advice.
What is Maven's investment approach?
Maven has a generalist investment focus, with and the collective skills and experience to invest across a wide range of industry sectors and a broad geographical base. The objective for each Maven VCT is to continually develop and expand the portfolio, maintaining a regular turnover of assets through a cycle of investment, realisation, distribution of dividends, re-investment and fundraising, to continue growing the portfolio.
Maven is also one of the few managers in the market able to offer a dual private company and AIM portfolio strategy, which allows each of its VCTs to maximise portfolio and sector diversification and spread investment risk across large, broadly based portfolios. Maven believes that a hybrid private company and AIM strategy provides the best approach for optimising Shareholder returns, combining the long term capital return potential of high-growth private company assets with the ability to achieve shorter term returns from carefully selected AIM investments.
Since January 2016, following VCT rule changes that required VCTs to focus on earlier stage private companies, Maven has been one of the most active managers in the industry, completing new investments in high growth businesses active in defensive sectors such as software, cyber security, life sciences, biotech, web archiving, data analytics, fintech, training, medtech and healthcare.
Maven has a nationwide presence through a regional office network and investment team capable of completing VCT qualifying investments and then working closely with each investee company to provide ongoing strategic and operational support, before pursuing a sale. Maven’s experienced team offers specialist knowledge of growth capital and early stage investment across a diverse range of industry sectors, as well as a specialist London-based AIM team.
How does Maven select its VCT assets?
The Maven VCTs have a history of backing entrepreneurial businesses in some of the UK’s most vibrant sectors, where Maven’s multi sector expertise allows our nationwide team to source and execute attractive new private and AIM listed investments across the regional markets, focusing on those companies able to embrace innovation, exploit market opportunities and create skilled employment.
Maven targets investment across a wide range of sectors, in carefully vetted private companies that have strong core characteristics, and which are each led by a capable management team with a proven track record in their current or a previous business. This approach, underpinned by Maven’s many years of experience in investing in SMEs, helps to mitigate the underlying investment risk inherent in earlier stage private company investment.
Maven looks to invest in companies which have proprietary technology, intellectual property or a business model that has the potential to improve shareholder value by having a significant impact on its sector or market, either by displacing existing products, or by creating a new or enhanced product or service.
Maven’s regional business model ensures that our team are introduced to a consistent flow of new opportunities, across a wide range of sectors, and allows Maven to take a highly selective approach to private company investment, aiming to only support companies which have the potential to deliver sustainable growth in revenues, and where investment can be secured at an entry price that offers the prospect of attractive returns in the future. Our specialist AIM team, operating from our London office and well known to the key broker community, also sources and makes selected new quoted investments on behalf of the VCTs.
How does Maven manage investment risk?
With over 250 years’ collective experience of investing in UK private companies, the Maven team has a structured approach to identifying and managing the risk associated with VCT investment. We have developed a rigorous selection process, investing only at attractive entry prices in businesses run by proven management teams we believe can deliver value for all investors at exit. Each VCT holds a diverse range of investments, generally with a broad base of 50 to 60 private company investments focussed on medium to long term growth, alongside selected AIM investments which may offer the potential for shorter term returns based on news flow and share price performance. We believe this hybrid portfolio approach is the optimal strategy for a VCT, and helps reduce the risk of investing in a narrow or single market basis.
At portfolio company level, Maven uses a range of risk mitigation strategies, including investing progressively in stages or tranches, making an initial commitment amount in tandem with an expectation of providing follow-on funding if the business achieves agreed commercial milestones. Maven will also often co-invest in certain transactions alongside Maven managed non-VCT funds or with other experienced Private equity investment managers, allowing each VCT to spread portfolio risk by completing a large number of investments.
This considered approach allows each VCT to maximise the potential for long term capital appreciation and tax free dividends from a widely diversified portfolio of entrepreneurial small businesses, across different asset classes - private equity and AIM.
How does Maven manage its VCT portfolio after making an investment?
Maven is committed to supporting our portfolio businesses throughout the investment period. We aim to build strong relationships with the management teams we back and will support them in delivering their growth strategy and ambitions for the business, ultimately with the aim of driving increased shareholder value.
Although young, earlier stage businesses offer the potential for attractive and rapid growth, they often have less in-house Management or business expertise than larger more mature businesses. A well resourced VCT manager will have the expertise to help support the team, particularly as it undertakes strategic initiatives such as developing new product lines, internationalising its operations or identifying potential acquisitions.
Ready to invest?
Visit our VCT Offers page or contact our team if you want more information about the current VCT Offers open for investment.
- Home /
- VCTs /
- About VCTs







